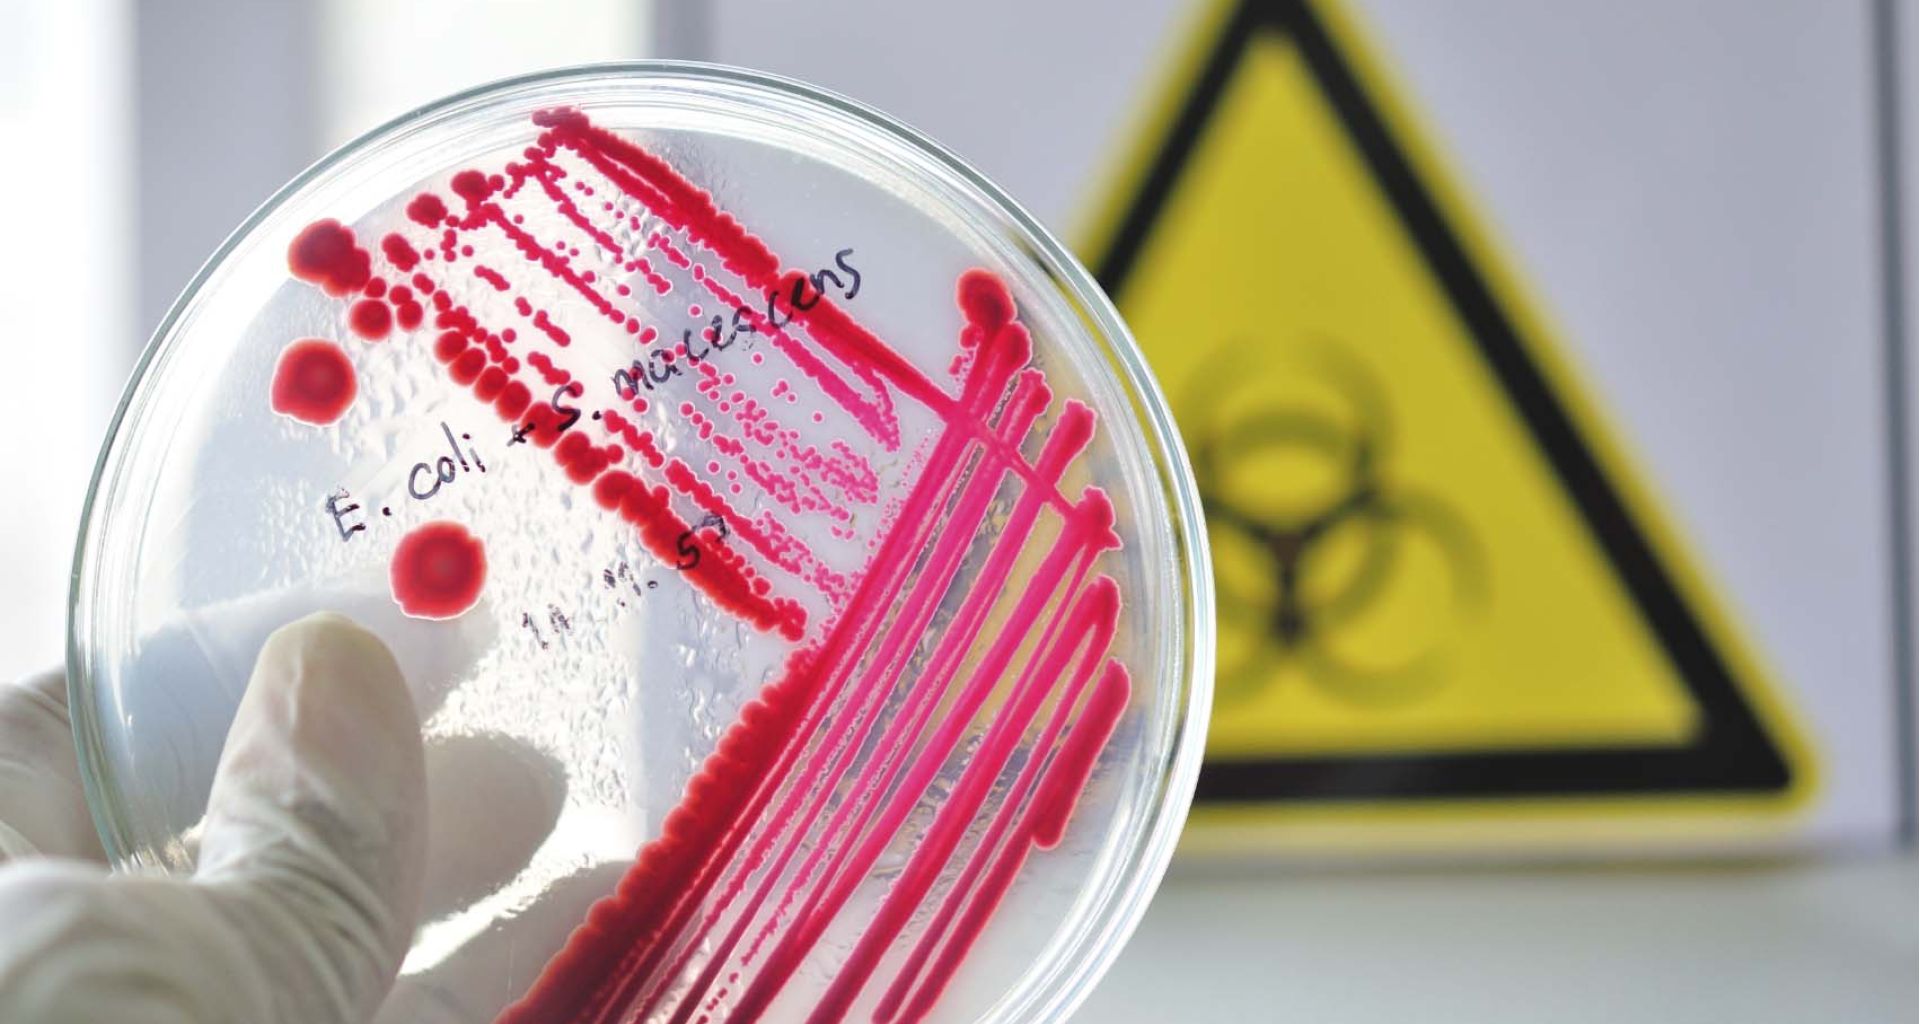
الميكروبات الممرضة: قدرة بقاءها حية في المخلفات الطبية 5 الميكروبات الممرضة: قدرة بقاءها حية في المخلفات الطبية

الميكروبات الممرضة: قدرة بقاءها حية في المخلفات الطبية
هناك أجماع عالمي في كل اللوائح واللإجراءات والقواعد التنظيمية التي تخص صحة الإنسان أن هناك حاجة إلى المزيد من الوعي حول المخاطر البيئية والصحية التي تنطوي عليها إدارة النفايات الطبية. ولا يمكن معرفة عوامل الخطر على صحة الإنسان والبيئة المتعلقة بهذا النوع من النفايات إلا عن طريق معرفة المخاطر المرتبطة بالميكروبات نفسها الموجودة بداخل النفايات […]
هناك أجماع عالمي في كل اللوائح واللإجراءات والقواعد التنظيمية التي تخص صحة الإنسان أن هناك حاجة إلى المزيد من الوعي حول المخاطر البيئية والصحية التي تنطوي عليها إدارة النفايات الطبية. ولا يمكن معرفة عوامل الخطر على صحة الإنسان والبيئة المتعلقة بهذا النوع من النفايات إلا عن طريق معرفة المخاطر المرتبطة بالميكروبات نفسها الموجودة بداخل النفايات من حيث خطورتها وتسببها بالأمراض وطرق أنتقالها وسرعة انتشارها في البيئة أو الأهم من حيث مقاومتها للظروف البيئية أو بقاءها حية ونجاتها بعد مرورها عبر طرق مختلفة في معالجة النفايات.
من ضمن الأشياء التي تعطي الميكروبات الممرضة خطورة عن باقي الميكروبات هي قدرتها على الصمود والبقاء حية في الظروف الصعية أو الظروف البيئية الغير ملائمة لها. وهذا ما سنتكلم عنه في هذه المقالة، وهو مقدرة بقاء الميكروبات حية في الظروف البيئية الصعبة لأزمنة طويلة في أختلاف درجات الحرارة التي تناسبها وتفضلها للتكاثر والنمو أو في بيئة تقل فيها الرطوبة أو تزيد أو في وجود عوامل خارجية مزعجة مثل الأشعة البنفسجية أو في أنعدام وجود مواد عضوية كافية لبقاءها حية.
أولاً: دراسات عن مقدرة الميكروبات على البقاء حية في النفايات الطبية:
الدراسة الأولى
أجرى فريق بحثي من كوريا الجنوبية دراسة على أنواع وتركيزات الميكروبات الممرضة الموجودة في مختلف أنواع المخلفات الطبية وكذلك درس مقدرة بقاءها حية في تلك النفايات وفي مختلف دراجات الحرارة لتقييم وتقدير معدل الخطورة الميكروبية فيها (Microbial Risk Assessment)، حيث جمع الباحث في الدراسة مخلفات طبية متنوعة من خمسة مستشفيات مختلفة تم تخزينها في ثلاث دراجات حرارة مختلفة (-20، 6، 30 درجة مئوية)، وتم تحديد المحتوى الميكروبي من الفيروسات والبكتيريا بأستعمال طرق الزرع المعتادة في أطباق المزارع البكثيرية وبطريقة (RT-PCR assays) فتحصل على النتائج التالية:
1- البكتيريا الممرضة: Pseudomonas spp., Lactobacillus spp., Staphylococcus spp., Micrococcus spp., Microbacterium oxydans, Propionibacterium acnes, Kocuria spp., Brevibacillus spp.
2- الفيروسات الممرضة: تم التعرف على فيروسات ضارة مثل فيروس نوروفيروس (Noroviruses) وفيروس تليف الكبد البائي (HBV) في مخلفات أنسجة بشرية.
في الخطوة التانية من الدراسة تم حقن غالبية البكتيريا والفيروسات التي عزلت في الشاش وفي الحفاظات (شبيه لبيئة المخلفات الطبية) لقياس معدل نجاتها وبقاءها حية في عدة ظروف صعبة وغير ملائمة، وقد أظهر فيروس Noroviruses ضعفاً في صموده ضد العوامل البيئية الصعبة، كما أظهرت الدراسة أن العديد من مسببات الأمراض يمكن أن تكون موجودة في النفايات الطبية ولكن يبدو أن المخاطر الصحية المرتبطة بها تكون منخفضة، ومع ذلك، يجب مراقبة النفايات الطبية بعناية كبيرة والتخلص منها بالطرق العلمية الصحيحة لمنع العدوى غير المصاحبة المرتبطة بالتعرض لهذه النفايات.
الدراسة الثانية
دراسة ميكروبية أخرى إجريت في الهند لتحديد أنواع البكتيريا في عينات من المخلفات الطبية جمعت من مستشفى جامعي، استعملت في الدراسة الطرق التقليدية في عزل البكتيريا وزرعها حيث أثبتت النتائج وجود بكتيريا العصوية (Bacillus subtilis) بنسبة 12% في النفايات الطبية، والبكتيريا العنقودية الذهبية (Staphylococcus aureus) بنسبة 9% وبكتيريا العصوية المسببة لالتهابات الرئوي (Klebsiella pneumonia) بنسبة 6%، وبكتيريا القالونية (Escherichia coli) بنسبة 15%. كم ذكر في الدراسة أن كتل النفايات الطبية تحتوي كذلك على كميات كبيرة من البكتيريا النافعة والتي يمكن أستخدامها في معالجة النفايات المستشفى الغير معدية (Biodegradation) للإستفادة منها

الدراسة الثالثة
عدة دراسات أخرى إجريت حول مقاومة الميكرويات وبقاءها حية في الإبر والحقن بالذات لأنهم أكبر مصادر للخطر فمن النفايات الطبية في المرافق الصحية، وأكثر الإصابات تحدث بسبب إعادة أستعمال تلك الإبر والحقن الموجودة في المخلفات الطبية من قبل المتعاطين للمخذرات.

يعتبر فيروس تليف الكبد الجيمي (HCV) من أكثر الفيروسات الدم التي تصيب متعاطي المخذرات عبر إعادة أستخدام الحقن الملوثة بالدماء حسب التقارير الطبية للعديد من المنظمات الصحية، فنسبة الإصابة قد تصل ألى 95% من نسبة المدمنين. ولدراسة صمود وبقاء الفيروسات في هذه الحقن إجريت دراسة أمريكية حول مقدرة صمود وبقاء فيروس تليف الكبد الجيمي (HCV) في حقن الأنسولين (Insulin syringes) وحقن التيبوركولين (Tuberculin syringes) الملوثة بالدماء. فتمت دراسة فعالية الفيروسات وبقاءه حية في حقن ملوثة بالدم خزنت في درجات حرارة مختلفة (4، 22، 37 درجة مئوية) ولمدة حتى 63 يوم. فكانت النتائج الدراسة كالتالي:
حقن ألأنسولين: دراسة أثبتت عدم بقاء الفيروس حي في كل درجات الحرارة لأكثر من يوم واحد فقط ماعدا درجة حرارة 4 درجة مئوية حيث بقاء الفيروس حي لمدة 7 أيام.
حقن التيبوركولين: بقاء الفيروس حي بنسبة 96% ، 71%، 52% على درجات الحرارة كتوالي 4، 22، 37 درجة مئوية لمدة 7 أيام.
توصلت الدراسة الى ملخص نهائي بأن من أسباب معدلات الإصابات العالية بفيروس تليف الكبد الجيمي راجع لمقدرة هذا الفيروس على البقاء حي في أنواع الحقن المستعملة في التعاطي وهذه النتيجة يمكن أن توخذ في برامج مكافحة تعاطي المخذرات عبر الحقن فنوعية الحقنة عامل مهم كذلك. توصلت الدراسة بأن الحقن والإبر المرمية مع النفايات الطبية تعتبر مصدر خطر كبير للإصابة بفيروسات الدم وذلك لمقدرة الفيروس على البقاء حي لأزمنة طويلة في داخل تلك الحقن والإبر.

أختلاف مقاومة الميكروبات الممرضة (الفيروسات والبكتيريا والطفيليات) للظروف البيئية المختلفة
بالتأكيد تختلف الميكروبات الممرضة في درجة مقاومتها ومدى مقدرتها في البقاء حية في أختلاف البيئة التي تفضلها. إجريت العديد من الدراسات في هذه النقطة بالذات لتحديد قدرة مقاومتها بهذف معرفة كل ما يتعلق بالميكروب الممرض وذلك للمساعدة الباحثين الأخرين في وضع برامج ناجحة لمكافحة تلك الميكروبات والوصول لبرامج معالجة فعالة ضد الميكروبات.
1) الفيروسات الممرضة
عدة دراسات ميكروبية حول قدرة بقاء الميكروبات في البيئات الصعبة ركزت على الفيروسات بصفة عامة وبالأخص فيروسات الدم مثل فيروس تليف الكبد البائي والجيمي وفيروس الإيدز والتي تعتبر من أكثر الفيروسات التي حدتث منها إصابات في العاملين في قطاع الصحة فقد درست من حيث صمودها وبقاءها حية في ظروف غير ملائمة:
- فيروس تليف الكبد البائي (HBV): وجد البحاث بأن فيروس تليف الكبد البائي يبقى حي على سطح جاف لعدة أسابيع ولمدة أسبوع على سطح درجة حرارته 25 درجة مئوية ويبقى لعدة أسابيع في قطرات الدم الجاف ولمدة 10 ساعات في درجة حرارة 60 درجة مئوية ويبقى حي في سائل بتركيز 70% كحول الاثانول.
- فيروس الكبد الجيمي (HCV): فيروس تليف الكبد الجيمي يستطيع البقاء حي في الدم على درجة 4 درجات مئوية لمدة أسبوع كامل.
- فيروس الإيدز (HIV): اما بالنسبة لفيروسات مرض فقد المناعة المكتسبة (الإيدز) فاحتمال بقاءه حي في هواء الطلق من 3- 7 أيام، ويصبح غير نشط مع درجة حرارة 56 درجة مئوية ويمكن أن يصمد في سائل به كحول الأثانول لتركيز 70% لمدة 15 الدقيقة، ويمكن له الصمود لمدة 21 يوما في قطرة دم في الدرجة الحرارة العادية، بصفة عامة يعتبر فيروس الإيدز هش بالمقارنة بفيروس تليف الكبد البائي فالجفاف يقلل من نسبة تركيز الفيروسات من 90- 99% في خلال ساعات قليلة.
- فيروس شلل الأطفال (Poliovirus): يستطيع البقاء حي من 20- 170 يوم.
- فيروس الأنفلونزا يستطيع البقاء على الأسطح الجامدة من يوم إلى يومين.
- فيروس (Feline calicivirus) يستطيع البقاء حي على الأسطح الجامدة من 8 ساعات إلى 7 أيام.

2) البكتيريا الممرضة
دراسات أخرى شملت كذلك مقدرة بقاء البكتيريا في كتل من النفايات أو مقدرة بقاءها على الأسطح الجامدة فكانت نتائج كالتالي:
- أظهرت دراسة بأن ميكروب السل (Mycobacterium tuberculosis) له قابلية للبقاء حي في النفايات الصلبة لمدة 180 يوماً. وفي دراسة أخرى أثبتت إصابة ثلاث عمال في محطة معالجة نفايات طبية بميكروب السل نتيجة وجوده في النفايات الطبية الصلبة والتي لم يتم علاجها مبدئياً، وهذه الدراسة أكدت صمود ميكروب السل في هذه البيئة.
- بكتيريا السلامونيلا الثيوفودية (Salmonella typhi) المسببة لمرض الحمى الثيفودية (Typhoid Fever) تستطيع الصمود من 29 إلى 70 يوم في كتلة من النفايات.
- تستطيع اللولبيات مثل (Leptospira interrogans) ف الصمود والبقاء حية إلى 15-43 يوماً في كتلة من النفايات.
- بكتيريا (Acinetobacter spp.) تستطيع البقاء على الأسطح الجامدة من 3 أيام إلى 5 أشهر
- بكثيريا (Clostridium difficile) تستطيع البقاء على الأسطح الجامدة لمدة 5 أشهر
- البكتيريا القالونية (Escherichia coli) من 1.5 ساعة إلى 16 الشهر
- بكتيريا (Enterococcus spp.) تستطيع البقاء من 5 ايام إلى 4 أشهر
- البكتيريا العنقودية الذهبية (Staph. aureus) بما فيها سلالة المارسا (MRSA) تستطيع البقاء على الأسطح الجامدة من سبعة ايام إلى سبعة أشهر.
- ميكروب عصيات الجمرة الخبيثة (Anthrax) تسطيع مقاومة الحرارة وأشعة الشمس والعديد من المطهرات، كما تستطيع البقاء حية لعقود في التربة وفي صوف الحيوانات، كما يمكن للعصيات في حالة الأبواغ (Anthrax spores) البقاء لمدة سنتين في الماء وعشرة سنوات في الحليب.
3) الطفيليات الممرضة
بعض الطفيليات أظهرت مقاومة كبيرة للبقاء حية في بعض الظروف الغير طبيعية بالنسبة لها:
- يستطيع طفيل الأمبيا الدسنتارية (Entamoeba histolytica) المسببة لمرض الدسنتاريا (Amoebic Dysentery) البقاء حية في كتلة نفايات لمدة 8- 12 يوماً.
- بيض طفيل الأسكارس (Ascaris lumbricoides) المسبب لمرض الأسكارس (Ascariasis) يستطيع الصمود والبقاء من 2000 إلى 2500 يوماً في كتلة من النفايات الطبية.
- بعض يرقات الديدان (Larvae) المسببة لأمراض الديدان معوية تستطيع الصمود والبقاء حية من 25 يوما إلى 40 يوما في كتل من النفايات الطبية.
في الختام وبصفة عامة، الميكروبات الممرضة عندها مقدرة محدودة جدا للبقاء حية في البيئة، البقاء يعتمد على الميكروب وحالة البيئة مثل الحرارة والرطوية والأشعة البنفسجية وتوفر المواد العضوية ووجود المطهرات، البكتيريا أقل مقاومة من الفيروسات والمعلومات لا زالت قليلة بخصوص مسببات بعض الأمراض العصبية (prions and the agents of degenerative neurological diseases) والتي تعتبر اكثر مقاومة من الفيروسات.
تعتبر تراكيز الميكروبات في المخلفات الطبية ليست أكثر من التي موجودة في النفايات المنزلية باستتناء نفايات المزارع البكتيرية بالمعامل التحاليل وبعض إفرازات المرضى بقسم الأمراض السارية. ولكن في كل الأحوال النفايات الطبية تحتوي على تشكيلة أكثر وأنواع شتىء من الميكروبات الممرضة وغيرها، وربما بقاء هذه الميكروبات حية يعتبر قليل بالمقارنة بالنفايات المنزلية بسبب وجود كمية اكبر من المواد المطهرة والكيماويات التي تستخدم في تطهير وتعقيم الجروح والإصابات.

References:
Hyeonjin Park, Keunhwa Lee, Misoon Kim, Jungeun Lee, Seung-Yong Seong & Gwangpyo Ko. (2009). Detection and hazard assessment of pathogenic microorganisms in medical wastes. Journal of Environmental Science and Health, Part A. Toxic/Hazardous Substances and Environmental Engineering Volume 44, 2009 – Issue 10
Kammy R. Johnson, et.al.,(2000). Transmission of Mycobacterium tuberculosis From Medical Waste JAMA. 2000;284(13):1683-1688.
Anitha J and Jayraaj IA. (2012). Isolation and identification of Bacteria from biomedical waste. International Journal of Pharmacy and Pharmaceutical Sciences. Vol 4, Suppl 5.
International Committee of the Red Cross. (2011). Geneva, Switzerland. November.
Elijah Paintsil, Huijie He, Christopher Peters, Brett . Lindenbach, and Robert Heimer. (2010). Survival of Hepatitis C Virus in Syringes: Implication for Transmission among Injection Drug Users. J Infect Dis. 2010 October 1; 202(7): 984–990.
Paintsil E, Verevochkin SV, Dukhovlinova E, et al. Hepatitis C virus infection among drug injectors in St Petersburg, Russia: social and molecular epidemiology of an endemic infection. Addiction 2009;104:1881–90.
MacDonald MA, Wodak AD, Dolan KA, van Beek I, Cunningham PH, Kaldor JM. Hepatitis C virus antibody prevalence among injecting drug users at selected needle and syringe programs in Australia, 1995–1997. Collaboration of Australian NSPs. Med J Aust 2000;172:57–61.
Hope VD, Judd A, Hickman M, et al. Prevalence of hepatitis C among injection drug users in England and Wales: is harm reduction working? Am J Public Health 2001;91:38–42.
Hagan H, Thiede H, Weiss NS, Hopkins SG, Duchin JS, Alexander ER. Sharing of drug preparation equipment as a risk factor for hepatitis C. Am J Public Health 2001;91:42–6.
Freeman AJ, Zekry A, Whybin LR, et al. Hepatitis C prevalence among Australian injecting drug users in the 1970s and profiles of virus genotypes in the 1970s and 1990s. Med J Aust 2000;172:588– 91.
Contamination and Cross Contamination on Hospital Surfaces and Medical Equipment. Saxe Healthcare Communications., www.initiatives-patientsafety.org, info@saxecommunications.com

اترك تعليقاً